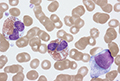
Лейкемия small

Базалиома – это злокачественные новообразования, развивающиеся из клеток базального слоя эпидермиса
Базалиома – это злокачественные новообразования, развивающиеся из клеток базального слоя эпидермиса
 Базально-клеточный рак кожи – это самая распространенная форма рака кожи. Опухоль чаще всего возникает на открытых участках кожи – таких, как голова, лицо, шея, руки и части туловища, на которые падают солнечные лучи. При своевременном выявлении базально-клеточный рак хорошо поддается лечению и редко метастазирует.
Базально-клеточный рак кожи – это самая распространенная форма рака кожи. Опухоль чаще всего возникает на открытых участках кожи – таких, как голова, лицо, шея, руки и части туловища, на которые падают солнечные лучи. При своевременном выявлении базально-клеточный рак хорошо поддается лечению и редко метастазирует.
Лейкемия – это злокачественное заболевание, которое также называют раком крови или белокровием, поскольку при нем в крови повышается содержание белых кровяных телец – лейкоцитов
Лейкемия – это злокачественное заболевание, которое также называют раком крови или белокровием, поскольку при нем в крови повышается содержание белых кровяных телец – лейкоцитов
 Лимфогранулематоз или болезнь Ходжкина – это злокачественная опухоль лимфоидной ткани со специфической гистологической структурой. Лимфогранулематоз часто встречается в детском возрасте, а также имеет пики заболеваемости в 20 и 50 лет. Этиология лимфогранулематоза неизвестна.
Лимфогранулематоз или болезнь Ходжкина – это злокачественная опухоль лимфоидной ткани со специфической гистологической структурой. Лимфогранулематоз часто встречается в детском возрасте, а также имеет пики заболеваемости в 20 и 50 лет. Этиология лимфогранулематоза неизвестна.
 Лимфома – это онкологическое заболевание, при котором источником злокачественности становится лимфатическая ткань. В процесс вовлекаются B- и T-лимфоциты
Лимфома – это онкологическое заболевание, при котором источником злокачественности становится лимфатическая ткань. В процесс вовлекаются B- и T-лимфоциты
 Лучевая терапия – это метод лечения опухолевых заболеваний с помощью ионизирующего облучения. Такое излучение создается с помощью специальных аппаратов, в которых используется радиоактивный источник. Суть метода заключается в том, что при облучении в активно делящихся клетках накапливается множество мутаций, которые приводят их к гибели. Лучевая терапия – это самостоятельная медицинская специальность, которой занимаются лучевые терапевты.
Лучевая терапия – это метод лечения опухолевых заболеваний с помощью ионизирующего облучения. Такое излучение создается с помощью специальных аппаратов, в которых используется радиоактивный источник. Суть метода заключается в том, что при облучении в активно делящихся клетках накапливается множество мутаций, которые приводят их к гибели. Лучевая терапия – это самостоятельная медицинская специальность, которой занимаются лучевые терапевты. Меланома – это злокачественная опухоль кожи. Она развивается из меланоцитов – клеток, которые синтезируют пигмент меланин. К сожалению, это очень опасное злокачественное заболевание, которое с трудом поддается лечению и регулярно уносит жизни людей. Поскольку в большинстве случаев опухоль локализуется на коже, путем регулярных профилактических осмотров ее не трудно обнаружить на ранних стадиях, когда еще возможно излечение.
Меланома – это злокачественная опухоль кожи. Она развивается из меланоцитов – клеток, которые синтезируют пигмент меланин. К сожалению, это очень опасное злокачественное заболевание, которое с трудом поддается лечению и регулярно уносит жизни людей. Поскольку в большинстве случаев опухоль локализуется на коже, путем регулярных профилактических осмотров ее не трудно обнаружить на ранних стадиях, когда еще возможно излечение.
 Онкологические больные имеют очень лабильную, уязвимую психику, что необходимо иметь в виду на всех этапах лечения и обслуживания этих больных. Вопрос о том, нужно ли сообщать больному диагноз, до сих пор остается неоднозначным и вызывает споры. Часть пациентов, услышав диагноз, мобилизуют все свои силы на борьбу с заболеванием, другие – могут испугаться и впасть в отчаяние. На Западе и в Америке принято полностью информировать пациента о его состоянии и рисках. В нашей стране об онкологическом заболевании часто сообщают не самому больному, а его родственникам.
Онкологические больные имеют очень лабильную, уязвимую психику, что необходимо иметь в виду на всех этапах лечения и обслуживания этих больных. Вопрос о том, нужно ли сообщать больному диагноз, до сих пор остается неоднозначным и вызывает споры. Часть пациентов, услышав диагноз, мобилизуют все свои силы на борьбу с заболеванием, другие – могут испугаться и впасть в отчаяние. На Западе и в Америке принято полностью информировать пациента о его состоянии и рисках. В нашей стране об онкологическом заболевании часто сообщают не самому больному, а его родственникам.
 Острый лейкоз – быстро развивающаяся форма рака, при которой патологически измененные лейкоциты накапливаются в крови и в костном мозге. Существует несколько видов острого лейкоза. Так называемый острый лимфобластный лейкоз чаще всего возникает у детей. Другой тип – острый гранулоцитарный лейкоз чаще встречается у взрослых.
Острый лейкоз – быстро развивающаяся форма рака, при которой патологически измененные лейкоциты накапливаются в крови и в костном мозге. Существует несколько видов острого лейкоза. Так называемый острый лимфобластный лейкоз чаще всего возникает у детей. Другой тип – острый гранулоцитарный лейкоз чаще встречается у взрослых.
 Термин "химиотерапия" обычно употребляется применительно к лечению злокачественных заболеваний. Существует множество противоопухолевых препаратов и с каждым днем специалисты разрабатывают все новые. Преимуществом химиотерапии перед другими методами лечения злокачественных новообразований является системность действия (хирургический метод или радиотерапия оказывают локальное воздействие на основной очаг заболевания).
Термин "химиотерапия" обычно употребляется применительно к лечению злокачественных заболеваний. Существует множество противоопухолевых препаратов и с каждым днем специалисты разрабатывают все новые. Преимуществом химиотерапии перед другими методами лечения злокачественных новообразований является системность действия (хирургический метод или радиотерапия оказывают локальное воздействие на основной очаг заболевания).
 Рак – это быстрое, хаотичное и неконтролируемое деление клеток, которое приводит к возникновению опухоли в органе или в ткани. Эти делящиеся клетки иногда распространяются в другие части тела через кровоток или лимфатическую систему. Во взрослом возрасте рак часто связан с процессом старения. Однако сегодня диагностика на ранней стадии и современные методы лечения могут справиться со многими видами рака.
Рак – это быстрое, хаотичное и неконтролируемое деление клеток, которое приводит к возникновению опухоли в органе или в ткани. Эти делящиеся клетки иногда распространяются в другие части тела через кровоток или лимфатическую систему. Во взрослом возрасте рак часто связан с процессом старения. Однако сегодня диагностика на ранней стадии и современные методы лечения могут справиться со многими видами рака.
 Рак желудка – это злокачественная опухоль, развивающаяся из слизистой оболочки желудка. В России рак желудка находится на втором месте по заболеваемости среди других новообразований, уступая раку легкого у мужчин и раку молочной железы у женщин. К сожалению, на ранних стадиях рак желудка практически никак не проявляется. Первые симптомы его не специфичны: слабость, быстрая утомляемость, похудание, снижение аппетита.
Рак желудка – это злокачественная опухоль, развивающаяся из слизистой оболочки желудка. В России рак желудка находится на втором месте по заболеваемости среди других новообразований, уступая раку легкого у мужчин и раку молочной железы у женщин. К сожалению, на ранних стадиях рак желудка практически никак не проявляется. Первые симптомы его не специфичны: слабость, быстрая утомляемость, похудание, снижение аппетита.
 В общей структуре онкологических заболеваний по частоте встречаемости злокачественные опухоли кожи занимают 3-е место. Среди злокачественных новообразований кожи наиболее часто встречается базальноклеточный рак, значительно реже – плоскоклеточный рак, меланома, и опухоли, развивающиеся из придатков кожи. Рак кожи возникает преимущественно на открытых частях тела, более 70% опухолей развивается на лице.
В общей структуре онкологических заболеваний по частоте встречаемости злокачественные опухоли кожи занимают 3-е место. Среди злокачественных новообразований кожи наиболее часто встречается базальноклеточный рак, значительно реже – плоскоклеточный рак, меланома, и опухоли, развивающиеся из придатков кожи. Рак кожи возникает преимущественно на открытых частях тела, более 70% опухолей развивается на лице. Рак легкого – это злокачественное новообразование, развивающееся из эпителиальной ткани легкого. Различают две формы: центральный рак легкого, исходящий из бронха, и периферический рак, развивающийся из самой ткани легкого. Рак легкого является одним из самых распространенных онкологических заболеваний.
Рак легкого – это злокачественное новообразование, развивающееся из эпителиальной ткани легкого. Различают две формы: центральный рак легкого, исходящий из бронха, и периферический рак, развивающийся из самой ткани легкого. Рак легкого является одним из самых распространенных онкологических заболеваний. Рак молочной железы занимает первое место среди всех злокачественнsх заболеваний у женщин. По статистике, заболеваемость населения России злокачественными новообразованиями молочной железы за последние 15 лет увеличилась более чем в 2 раза. Известно, что заболеваемость женщин, проживающих в крупных городах и индустриальных районах, выше, чем жительниц сельской местности.
Рак молочной железы занимает первое место среди всех злокачественнsх заболеваний у женщин. По статистике, заболеваемость населения России злокачественными новообразованиями молочной железы за последние 15 лет увеличилась более чем в 2 раза. Известно, что заболеваемость женщин, проживающих в крупных городах и индустриальных районах, выше, чем жительниц сельской местности.
 Рак мочевого пузыря составляет около 5% от всех злокачественных новообразований. Мужчины болеют в несколько раз чаще, чем женщины. Пик заболеваемости приходится на возраст от 50 до 80 лет. Рак мочевого пузыря – это одно из немногих злокачественных новообразований с с достоверно известными факторами канцерогенеза. Промышленные канцерогены вызывают 20% случаев заболевания.
Рак мочевого пузыря составляет около 5% от всех злокачественных новообразований. Мужчины болеют в несколько раз чаще, чем женщины. Пик заболеваемости приходится на возраст от 50 до 80 лет. Рак мочевого пузыря – это одно из немногих злокачественных новообразований с с достоверно известными факторами канцерогенеза. Промышленные канцерогены вызывают 20% случаев заболевания. Несмотря на все успехи современной науки, иногда врачи остаются бессильны перед болезнью. Как правило, речь идет о заболеваниях на поздних стадиях, когда обнаруживаются множественные метастазы, неоперабельная опухоль или ее устойчивость к лучевой и химиотерапии. В таких ситуациях единственная возможность помочь пациенту – паллиативное лечение. Паллиативная лечение – это помощь, обеспечивающая оптимальное качество жизни и комфорт пациента на стадии заболевания, когда специальное противоопухолевое лечение уже невозможно.
Несмотря на все успехи современной науки, иногда врачи остаются бессильны перед болезнью. Как правило, речь идет о заболеваниях на поздних стадиях, когда обнаруживаются множественные метастазы, неоперабельная опухоль или ее устойчивость к лучевой и химиотерапии. В таких ситуациях единственная возможность помочь пациенту – паллиативное лечение. Паллиативная лечение – это помощь, обеспечивающая оптимальное качество жизни и комфорт пациента на стадии заболевания, когда специальное противоопухолевое лечение уже невозможно.
 Рак почки составляет 3% злокачественных новообразований у взрослых и является самым распространенным вариантом опухоли почек у взрослых. Мужчины болеют вдвое чаще женщин. Большинство случаев приходится на возраст от 39 до 70 лет. К сожалению, рак почки может длительно протекать бессимптомно. Опухолевое образование часто выявляют случайно при проведении профилактического обследования. Хирургический метод является основным при лечении рака почки.
Рак почки составляет 3% злокачественных новообразований у взрослых и является самым распространенным вариантом опухоли почек у взрослых. Мужчины болеют вдвое чаще женщин. Большинство случаев приходится на возраст от 39 до 70 лет. К сожалению, рак почки может длительно протекать бессимптомно. Опухолевое образование часто выявляют случайно при проведении профилактического обследования. Хирургический метод является основным при лечении рака почки. Рак предстательной железы обычно возникает у людей, возраст которых старше 45-55 лет, у молодых людей такое новообразование встречается редко. По данным статистики заболеваемость раком предстательной железы в России доходит до 4.5%, при этом среди главных причин смерти рак предстательной железы находится на 5-м месте у мужчин в возрасте до 70 лет и на 4-м – у мужчин 70 лет и старше. Раковая опухоль растет медленно, и заболевание может никак не проявляться в течение многих лет.
Рак предстательной железы обычно возникает у людей, возраст которых старше 45-55 лет, у молодых людей такое новообразование встречается редко. По данным статистики заболеваемость раком предстательной железы в России доходит до 4.5%, при этом среди главных причин смерти рак предстательной железы находится на 5-м месте у мужчин в возрасте до 70 лет и на 4-м – у мужчин 70 лет и старше. Раковая опухоль растет медленно, и заболевание может никак не проявляться в течение многих лет.
 Рак прямой кишки составляет около 4-5% всех раковых заболеваний и является самой частой локализацией рака в кишечнике человека. Чаще всего рак прямой кишки выявляют в 40-60 лет.
Рак прямой кишки составляет около 4-5% всех раковых заболеваний и является самой частой локализацией рака в кишечнике человека. Чаще всего рак прямой кишки выявляют в 40-60 лет.
 Рак тела матки является самой распространенной злокачественной опухолью малого таза у женщин. Прогноз заболевания зависит от гистологического типа опухоли и распространенности опухолевого процесса. Чаще всего заболевание начинается в постменопаузе, 25% приходится на возраст моложе 50 лет, 5% на возраст моложе 40 лет.
Рак тела матки является самой распространенной злокачественной опухолью малого таза у женщин. Прогноз заболевания зависит от гистологического типа опухоли и распространенности опухолевого процесса. Чаще всего заболевание начинается в постменопаузе, 25% приходится на возраст моложе 50 лет, 5% на возраст моложе 40 лет.  Рак ободочной кишки – злокачественное заболевание, которое может локализоваться в любой части толстого отдела кишечника, состоящего из ободочной кишки (часть кишечника, через которую опорожняется тонкий отдел кишечника) и прямой кишки (конечная укороченная часть толстого отдела кишечника).
Рак ободочной кишки – злокачественное заболевание, которое может локализоваться в любой части толстого отдела кишечника, состоящего из ободочной кишки (часть кишечника, через которую опорожняется тонкий отдел кишечника) и прямой кишки (конечная укороченная часть толстого отдела кишечника).
 Рак шейки матки – достаточно распространенное заболевание женщин. Имеются два возрастных пика заболеваемости – 35-39 лет и 60-64 года. В России частота встречаемости составляет примерно 11 случаев на 100 000 населения.
Рак шейки матки – достаточно распространенное заболевание женщин. Имеются два возрастных пика заболеваемости – 35-39 лет и 60-64 года. В России частота встречаемости составляет примерно 11 случаев на 100 000 населения.
 Рак яичников занимает пятое место по частоте встречаемости среди злокачественных образований у женщин. В России заболеваемость раком яичника составляет приблизительно 77 случаев на 100 тысяч населения. Средний возраст, когда возникает рак яичников, составляет 61 год. Рак яичников на ранних стадиях протекает, как правило, бессимптомно. На более поздних стадиях может появляться учащенное мочеиспускание, запор, кровянистые выделения из влагалища, неприятные ощущения в животе.
Рак яичников занимает пятое место по частоте встречаемости среди злокачественных образований у женщин. В России заболеваемость раком яичника составляет приблизительно 77 случаев на 100 тысяч населения. Средний возраст, когда возникает рак яичников, составляет 61 год. Рак яичников на ранних стадиях протекает, как правило, бессимптомно. На более поздних стадиях может появляться учащенное мочеиспускание, запор, кровянистые выделения из влагалища, неприятные ощущения в животе.
 Химиоэмболизация – это метод местной химиотерапии при различных злокачественных новообразованиях. Суть метода заключается в эмболизации (закрытие просвета) артерии питающей опухоль эмболизирующим материалом, в составе которого содержится противоопухолевый препарат.
Химиоэмболизация – это метод местной химиотерапии при различных злокачественных новообразованиях. Суть метода заключается в эмболизации (закрытие просвета) артерии питающей опухоль эмболизирующим материалом, в составе которого содержится противоопухолевый препарат.
 Хронический лейкоз – форма рака крови, которая развивается медленно, иногда в течение 15-20 лет, и наблюдается чаще у пациентов пожилого возраста. Заболевание характеризуется накоплением лейкоцитов в крови и в костном мозге.
Хронический лейкоз – форма рака крови, которая развивается медленно, иногда в течение 15-20 лет, и наблюдается чаще у пациентов пожилого возраста. Заболевание характеризуется накоплением лейкоцитов в крови и в костном мозге.







